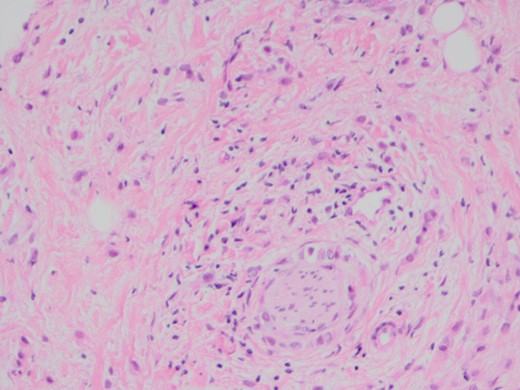
H and E stain demonstrating poorly differentiated carcinoma with perineural invasion.

-
PDF
- Split View
-
Views
-
Cite
Cite
Andrew Zammit, Daniel James, Petrus Henk Van Rooyen, Metastatic lobular breast carcinoma to the pancreas: a case report, Journal of Surgical Case Reports, Volume 2018, Issue 5, May 2018, rjy111, https://doi.org/10.1093/jscr/rjy111
Close - Share Icon Share
Abstract
We report a case of a 72-year-old female, with an extensive breast cancer history, who presented with abdominal pain to her general practitioner. Cross-sectional imaging demonstrated a lesion in the head of pancreas, which was not amenable to curative resection. Percutaneous biopsy was obtained, which demonstrated metastatic lobular breast cancer. This rare case highlights how previous medical histories may assist in final pathological diagnosis.
INTRODUCTION
We report a rare case of metastatic breast cancer spreading to the pancreas, which provides a lesson in how thorough history taking may assist in the final pathological diagnosis.
CASE REPORT
A 72-year-old female patient presented to her general practitioner with several months of generalized abdominal pain on the background of a breast cancer history. Nineteen years prior to presentation, she was diagnosed with a 9 mm ductal carcinoma of the left breast, which was treated with a wide local excision (original imaging unavailable). It was oestrogen receptor positive. A level II axillary clearance revealed no involved nodes. Post-operatively she received tamoxifen, which was ceased after 6 months due to side effects. Fourteen years later (5 years prior to this presentation) she represented with palpable left axillary lymphadenopathy. A core biopsy was suggestive of invasive breast carcinoma, however, no primary breast lesion was identifiable on bilateral mammogram, ultrasound and MRI scans. Completion level II axillary clearance was performed that demonstrated 7/7 positive lymph nodes for invasive lobular breast carcinoma with extra-nodal extension. Oestrogen receptor status was positive, progesterone receptor negative and HER-2 receptor negative. Post-operatively, repeat imaging once again failed to demonstrate a primary lesion. Staging CT scans of her chest, abdomen and pelvis were clear for metastatic disease. She was subsequently treated with exemestane and had regular surgical and medical oncology follow up, with no evidence of loco-regional recurrence.
When she now presented with generalized abdominal pain, a CT scan of the abdomen was performed, revealing a lesion in the head of the pancreas measuring 7 × 4 cm2. This mass extended into the porta hepatis and towards the left lobe of the liver, opacification of the splenic vein and superior mesenteric veins was absent, and the confluence of the portal vein could also not be visualized (Fig. 1). Total bilirubin was 13 μmol/L (normal <20), raised ALT at 127 U/L (normal <34) and AST at 69 U/L (normal <31). ALP and GGT were also mildly raised at 135 U/L for ALP (normal 30–110) and 219 U/L for GGT (normal <38). Carcinoembryonic antigen and CA19.9, both markers of pancreatic cancer, were not raised. She was referred to a hepatobiliary surgeon for consideration of a pancreaticoduodenectomy, with the assumption of a primary pancreatic lesion. Due to suspected vascular involvement and potential peritoneal disease seen on the CT, she was regarded as an unsuitable candidate for a pancreaticoduodenectomy. To consider the use of palliative chemotherapy, a percutaneous biopsy for tissue diagnosis was performed. Histology demonstrated a poorly differentiated tumour, surrounded by benign pancreatic tissue with focal areas of perineural invasion by GATA3 positive epithelial cells. These cells also stained positive for ER, K19 and CEA, but negative for PR, B72.3, E-cadherin and HER2. The final diagnosis was poorly differentiated lobular breast carcinoma. Unfortunately, we were unable to compare the expression profiles between the pathology from the axillary dissection and the metastatic disease (Figs 2–4).

Axial slice of portal-venous phase CT scan demonstrating lesion in the head of pancreas.
H and E stain demonstrating poorly differentiated carcinoma with perineural invasion.

The poorly differentiated carcinoma shows nuclear positivity for oestrogen receptor (IPX).
DISCUSSION
During 2017 the projected incidence for breast cancer in Australia is 17 000, representing one of the most prevalent cancer diagnoses [1]. In Western populations lobular breast carcinoma accounts for ~10% of all breast cancer diagnoses, and overall has a poorer prognosis than that of ductal breast carcinoma [2, 3]. Following this patient’s diagnosis, we investigated how frequently lobular breast carcinoma metastasizes to the pancreas. From the literature we identified only 12 other cases of invasive breast carcinoma metastasizing to the pancreas [4]. The literature also demonstrates the difficulty diagnosing metastatic spread of breast cancer to the pancreas. There are several reports of patients undergoing a pancreaticoduodenectomy and only subsequent operative histology revealing metastatic breast carcinoma [4]. Some authors have suggested that surgical resection may be appropriate for both symptom control and formal diagnosis [5, 6].
In this patient’s case, the hepatobiliary department felt that in the absence of obstructive jaundice, and the possibility of tumour vascular involvement, a pancreaticoduodenectomy would not improve her quality of life nor provide a survival advantage. Should there had been no vascular involvement, surgical resection may have been of benefit [6–8].
Whilst metastatic disease to the pancreas is uncommon, we would suggest that with the discovery of pancreatic lesions, metastatic disease always be considered, especially with a history of previous malignancy. A thorough history and the availability of previous pathology reports, may assist in final pathological diagnosis.
CONFLICT OF INTEREST STATEMENT
None declared.
![The poorly differentiated carcinoma shows nuclear positivity for GATA3 (IPX). GATA3 is commonly mutated in breast carcinoma and has been reported as indicative of metastatic breast carcinoma [9, 10].](https://oupdevcdn.silverchair-staging.com/oup/backfile/Content_public/Journal/jscr/2018/5/10.1093_jscr_rjy111/1/m_rjy111f03.jpeg?Expires=1768117683&Signature=eyIsyNDGEv5r~XFsMRSoysvptPvEefE181uwu5YnqaN1UobHN4DKFsfiNtea2PbeuMrIt1OkZdO6rAQIwYsvvC-d5CpLnQjAmBw-pKe5r~ZBRBYvBcWVVCZH-4wpe1HDBURJAykUU4uYXtjAIsz6kWbDeLzNPQe2ENK-LJ2hnJcLyS13RwI7tGae6O4n5k-7OXm26EZoQA2tTnQCcRozPLAQmGGTqqsJRFsJSXrKCD4MxSuVwrkDf496FEIPEb~TgFaav0f6nPiPPqwwu37gtz6XZqr6AMlIMFoGjUnJpXqPMNDDmtXCo5ptO7KGsrZvsGSU~iNqowPAK56NNb1cdw__&Key-Pair-Id=APKAIYYTVHKX7JZB5EAA)